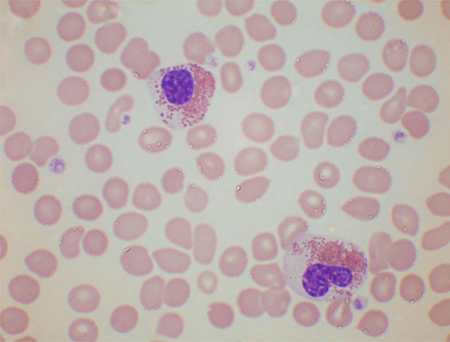

მიდგომა
ეოზინოფილია შეიძლება შემთხვევით აღმოაჩნდეს პაციენტს, რომელიც განსაკუთრებულად არაფერს უჩივის. თუ ანამნეზში აღინიშნება ალერგია (მაგ., ასთმა, თივისმიერი ცხელება, სეზონური რინიტი) და ეოზინოფილების რაოდენობა მხოლოდ მცირედ არის მომატებული (მაგ., 0.6 × 10⁹/ლ - 1.5 × 10⁹/ლ [600 - 1500/მიკროლიტრში]), შემდგომი კვლევები როგორც წესი, აღარ არის ნაჩვენები. თუ პაციენტს ეოზინოფილიასთან დაკავშირებული კანის რაიმე დაავადება აქვს (მაგ., ურტიკარია, ეგზემა, პემფიგუსი, ბულოზური პემფიგოიდი ან გესტაციური ჰერპესი), შემდგომი კვლევები ეოზინოფილიაზე აღარ არის ნაჩვენები (მდგომარეობის ეფექტური მართვისთვის აუცილებელი კვლვების გარდა).
თუ პაციენტი ცუდად გრძნობს თავს ან ეოზინოფილების რაოდენობა მნიშვნელოვნად არის მომატებული და მიზეზი გაურკვეველია, ნაჩვენებია გამოკვლევა. ასეთი კვლევა ზოგჯერ ურგენტულია (მაგ., გულის უკმარისობის დროს ან ეოზინოფილების ძალიან მაღალი რაოდენობისას).
ანამნეზი.
ეოზინოფილიის მქონე პაციენტების ანამნეზი პირველ რიგში უნდა მოიცავდეს არსებული ჩივილის შეფასებას, ორგანოთა სისტემების მიხედვით მიმოხილვას.
ალერგია
ანამნეზში უნდა გავითვალისწინოთ ცხელება, ეგზემა, ასთა ან ურტიკარია.
გეოგრაფიული ფაქტორები
უნდა გავარკვიოთ, პაციენტი ხომ არ ცხოვრობს ან უმოგზაურია პარაზიტებით ინფესტაციის ან კოკციდიოიდომიკოზის ენდემურ კერებში.
თუ პაციენტი ცხოვრობდა ან იმოგზაურა ტროპიკულ რეგიონში, მას უნდა გამოვკითხოთ ვიზიტის განმავლობაში ნიადაგსა ან მტკნარ წყალთან ექსპოზიციისა და პარაზიტულ დაავადებაზე მიმანიშნებელი ნებისმიერი სიმპტომის თაობაზე.
ყველა ტიპის მოგზაურობა (არა მხოლოდ ახლო წარსულში) მნიშნველოვანია (მაგ: სტრონგილოიდოზი შესაძლოა გამოვლინდეს ენდემური რეგიონის დატოვებიდან ათწლეულების შემდეგ, განსაკუთრებით, იმუნოსუპრესიული მდგომარეობის დროს).
HIV ინფექცია
უნა გავითვალისწინოთ აივ ინფექციის რისკფაქტორები, ვინაიდან აივ-დადებით პაციენტებს უფრო სავრაუდოა, ჰქონდეთ დისემინირებული პარაზიტული ან სოკოვანი ინფექციები, რომლებიც ხელს უწყობს ეოზინოფილიის განვითარებას.
მედიკამენტური ანამნეზი
უნდა შეგროვდეს მედიკამენტური ანამნეზი (განსაკუთრებით, ურეცეპტოდ გამოსაწერი მედიკამენტების, ახლადმიღებული [ჩვეულებრივ, 2-6 კვირის წინ დაწყებული] და იმუნოსუპრესიული სამკურნალო პრეპარატების შესახებ).
სულ ახლახან კორტიკოსტეროიდების ან სხვა იმუნოსუპრესიული მედიკამენტების გამოყენების ანამნეზი რელევანტურია, რადგანაც იმუნოსუპრესიულმა მკურნალობამ შესაძლოა გამოიწვიოს Strongyloides stercorali-თ ჰიპერინფესტაცია.
უნდა აღინიშნოს იღებს, თუ არა პაციენტი რაიმე პრეპარატს, რომლის გამოყენებაც ხშირად დაკავშირებულია არასასურველ რეაქციებთან (მაგ., სულფონამიდები, ცეფალოსპორინები, პენიცილინი, ნიტროფურანტოინი, კარბამაზეპინი, ალოპურინოლი, ფენიტოინი ან ოქროს პრეპარატები). ცხელება, გამონაყარი, ლიმფადენოპათია და ღვიძლის ფუნქციური ტესტების დარღვევა შესაძლოა მიუთითებდეს მედიკამენტების არასასურველ ეფექტებზე.
ანამნეზში გამონაყარი ან ლიმფადენოპათია.
ეს ეხება არა მხოლოდ წამლის რეაქციებს, არამედ კანის პირველად დაავადებებსაც, რომლებმაც შეიძლება გამოიწვიოს ეოზინოფილია. ლეიკემიამ, ლიმფომამ ან სისტემურმა მასტოციტოზმა შეიძლება გამოიწვიოს ორივე, გამონაყარიც და ლიმფადენოპათიაც.
ანამნეზში გულის დაავადება
კარდიული სიმპტომები (მაგ: ქოშინი, ტკივილი გულმკერდის არეში, გულის ფრიალი) პაციენტთან, გამოხატული ან გახანგრძლივებული ეოზინოფილიით, შესაძლოა მიუთითებდეს ეოზინოფილური პროდუქტებით გულის დაზიანებაზე. გულის ეოზინოფილური დაავადება კლინიკურად ურგენტული სიტუაციაა.
სხვა ორგანოსთან დაკავშირებული სიმპტომები
სპეციფიკურ ორგანოთა სისტემებთან დაკავშირებული სიმპტომები შესაძლოა მიუთითებდეს განსაზღვრულ ანთებით დაავადებაზე, როგორიცაა, დისფაგია ეოზინოფილური ეზოფაგიტის დროს ან მუცლის ტკივილი და დიარეა ეოზინოფილური გასტროენტერიტის დროს.[12][13][14][15]
ლიმფომის სიმპტომები
აუცილებლად უნდა გამოვიკითხოთ ლიმფომის ყველა სიმპტომი: ცხელება, ღამის ოფლიანობა, წონის კლება, ქავილი და ალკოჰოლით გამოწვეული ტკივილი.
ეპიზოდური სიმპტომები
გასათვალისწინებელია ისეთი სიმპტომები, როგორიცაა წონის ეპიზოდური მატება და ეპიზოდური ანგიოედემა, რადგანაც ის აღინიშნება გლაიჩის სინდრომის იშვიათ შემთხვევაში (ეპიზოდური ანგიოედემა ეოზინოფილიით).
ფიზიკური გამოკვლევა
უნდა ჩაიწეროს პაციენტის ტემპერატურის მაჩვენებელი. ცხელება შესაძლოა მიუთითებდეს პარაზიტებით ინფესტაციაზე, ან სოკოვან ინფექციაზე, ან მედიკამენტურ რეაქციაზე.
კანი უნდა შევამოწმოთ ერითემაზე, ეგზემატოზურ გამონაყარზე, შეშუპებაზე, ურტიკარიაზე ან კანის ინფილტრაციაზე. აღნიშნული შესაძლოა მიუთითებდეს კანის პირველად დაავადებაზე, მედიკამენტურ რეაქციაზე, ზოგიერთ პარაზიტულ ინფექციაზე, ეოზინოფილურ ლეიკემიაზე, პიგმენტურ ურტიკარიაზე, რომელიც დაკავშირებულია სისტემურ მასტოციტოზთან, კანის T-უჯრედულ ლიმფომასთან ან ციკლურ ანგიოედემასთან ეოზინოფილიით.
უნდა დათვალიერდეს ვასკულიტის ან პერიფერიული იშემიის ნიშნები. აღნიშნული შესაძლოა მიუთითებდეს პირველად სისხლძარღვოვან მდგომარეობაზე, როგორიცაა ეოზინოფილური გრანულომატოზი პოლიანგიიტით (ადრე ცნობილი, როგორც ჩარგ-შტრაუსის სინდრომი) ან შესაძლოა თვითონ იყოს ჰიპერეოზინოფილიის ნიშანი. ორივე შემთხვევაში მიუთითებს შესაძლო კლინიკურად ურგენტულ მდგომარეობაზე.
ბრონქოსპაზმი შეიძლება იყოს ასთმის, ალერგიული ბრონქოპულმონური ასპერგილოზის ან მძიმე მედიკამენტური რეაქციის დამახასიათებელი ნიშანი. სხვა რესპირატორული სიმპტომები (როგორიცაა ხველა, ქოშინი ან ხიხინი) შეიძლება მიუთითებდეს პარაზიტის მიგრაციაზე ფილტვებში, რომელიც დაკავშირებულია სიცოცხლის ციკლთან, წამლის რეაქციასთან ან ეოზინოფილურ ლეიკემიასთან. შისტოსომოზმა შეიძლება გამოიწვიოს პულმონური ჰიპერტენზია, ხოლო ეოზინოფილურმა გრანულომატოზმა პოლიანგიიტით - ფილტვის ინფილტრატები.[16]
ლიმფადენოპათიისთვის უნდა გავსინჯოთ ყველა ლიმფური კვანძის მიდამო. თუ კვანძები გადიდებულია, უნდა შეფასდეს მათი ზომა და სიმკვრივე, რადგანაც აღნიშნული შეიძლება მიუთითებდეს შესაძლო ნეოპლაზიაზე (მაგ: ლიმფომა, ან ლიმფოიდური ან მიელოიდური ლეიკემია); მკვრივი, ფიქსირებული, უმტკივნეულო კვანძები უფრო შესაძლოა იყოს ავთვისებიანი მდგომარეობის გამო.
ჰეპატომეგალია და სპლენომეგალია შესაძლოა იყოს ლიმფომის ან ეოზინოფილური ლეიკემიის ნიშანი.
კარდიომეგალია, არითმია ან გულის უკმარისობა შესაძლოა მიუთითებდეს გულის დაზიანებაზე ეოზინოფილებით და კლინიკურად ურგენტულ მდგომარეობაზე.
ნეიროპათია შესაძლოა მიუთითებდეს ეოზინოფილური ცილებით დაზიანებაზე.
კვლევები
ეოზინოფილიის დასადასტურებლად და ეოზინოფილების რაოდენობის აღრიცხვისთვის უნდა გაკეთდეს სისხლის საერთო ანალიზი (FBC). CBC და სისხლის ნაცხი ასევე უნდა იქნას გამოყენებული იდენტიფიცირებისთვის:[17]
ძირითადი ჰემატოლოგიური ავთვისებიანი სიმსივნე (მაგ. ბლასტური უჯრედები, ნეიტროფილია მარცხნივ გადაადგილებით, მონოციტოზი, ბაზოფილია, დისპლასტიკური მახასიათებლები და ლიმფომის უჯრედები)
თრომბოციტოზი, რაც შესაძლოა მეორეულად განვითარდეს ინფექციის, ანთების, ჰემორაგიის ან ავთვისებიანი მდგომარეობების, ასევე გარკვეული ჰემატოლოგიური დაავადებების (როგორიცაა, ქრონიკული მიელოიდური ლეიკემია, ესენციური თრომბოციტოპენია, ჭეშმარიტი პოლიციტემია) შემდგომ.
პარაზიტული ინფექციის ნიშნები (მაგ. მიკროფილარიების არსებობა).
უნდა აღინიშნოს, რომ ეოზინოფილური ციტოლოგიური დარღვევები შეიძლება გამოვლინდეს როგორც რეაქტიული ეოზინოფილიის, ასევე ეოზინოფილური ლეიკემიის დროს და შეიძლება ყოველთვის არ იყოს გამოსადეგი სავარაუდო ეოზინოფილური ლეიკემიის იდენტიფიცირებისთვის.[18]
თუ საეჭვოა პარაზიტული ინფესტაცია
განავლის სამი სხვადასხვა ადგილიდან აღებული ნიმუშები უნდა გამოვიკვლიოთ კვერცხებზე, ცისტებსა და პარაზიტებზე. აღნიშნული განსაკუთრებით ინფორმატიულია კლონორქოზის, ოპისტორქოზის, შისტოსომოზის, ანკილოსტომით ინფესტაციის, ასკარიდოზის და სტროინგილოიდოზის ნიშნების ძებნისას.[19]
სეროლოგიურ ტესტს შეუძლია გამოავლინოს სტრონგილოიდიაზი, შისტოსომიოზი (განსაკუთრებით თუ პაციენტი იმოგზაურა ან ცხოვრობდა აფრიკაში), ფილარიოზი (განსაკუთრებით დასავლეთ აფრიკაში), ტოქსოკარიოზი, ცისტიცერკოზი, ექინოკოკოზი, ანგიოსტრონგილოზი და გნატოსტომიაზი.[20]
Schistosoma haematobium დეტექციისთვის შარდის გამოკვლევა ძირითადი მეთოდია.
პარაზიტების იდენტიფიცირებისთვის ზოგიერთ კლინიკურ სიტუაციაში შესაძლოა საჭირო გახდეს ნახველის, ბრონქოალვეოლური ლავაჟის გამოკვლევა ან ენდოსკოპია.
კოკციდიოიდომიკოზი გასათვალიწინებელია პირებში, კალიფორნიასა ან არიზონაში მოგზაურობის შემდეგ. მისი იდენტიფიცირება შესაძლებელია სეროლოგიით, მაგრამ რეკომენდებულია ერთზე მეტი დიაგნოსტიკური ტესტის გამოყენება, რადგან ამჟამად არსებული მტკიცებულებებით მხარდაჭერილი არ არის ერთი საუკეთესო ტესტი.[21]გულმკერდის რენტგენოგრაფიაზე ჩანს წილოვანი პნევმონია, ხოლო ნახველის მიკროსკოპიით და კულტურით შესაძლებელია მიკროორგანიზმის იდენტიფიცირება. ერითროციტების დალექვის სიჩქარე (ESR) შეიძლება იყოს მომატებული.[22]
თუ საეჭვოა ავთვისებიანი მდგომარეობა
შემდგომი ტესტირება განისაზღვრება კლინიკური სურათის მიხედვით. ლეიკემია დიაგნოსტირდება სისხლის ნაცხის, ძვლის ტვინის ანალიზისა და სხვა ანალიზების შედეგებთან ერთად, რაც დამოკიდებულია სხვადასხვა სპეციფიკური ტიპებისა და ქვეტიპების არსებობაზე.
ეოზინოფილური ლეიკემიის დიაგნოსტირება, დაკავშირებულია რა PDGFRA ან PDGFRB-ის გადაწყობასთან, მნიშვნელოვანია თიროზინკინაზას ინჰიბიტორებით მკურნალობაზე მათი სენსიტიურობის გამო.[23][24] უნდა აღინიშნოს, რომ იშვიათი პაციენტები PDGFRA გადაწყობებით და PDGFRB გადაწყობის მქონე პაციენტების მნიშვნელოვან ნაწილს არ აღენიშნებათ ჰიპერეოზინოფილია, ამიტომ ეოზინოფილების ნორმალური რაოდენობა არ შეიძლება გამოყენებულ იქნას ამ პირობების გამოსარიცხად.[25]
ასევე ხელმისაწვდომია სპეციფიკური მედიკამენტები ეოზინოფილური ლეიკემიის სამკურნალოდ, რომელიც დაკავშირებულია FGFR1-ის გადაკეთებასთან, ამიტომ ეს დიაგნოზი შეიძლება ასევე იყოს მნიშვნელოვანი.[26]
ლიმფომის დასკვნითი დიაგნოზი ლიმფური კვანძის ექსციზიური ბიოფსიით დგინდება.
თუ დიფერენციული დიაგნოზი მოიცავს სისტემურ მასტოციტოზს ან ქრონიკულ ეოზინოფილურ ლეიკემიას, უნდა მოვითხოვოთ შრატის ტრიპტაზაზე ანალიზი.[17]
კანის დაავადება
როგორც პემფიგუსს, ისე ბულოზურ პემფიგოიდს აქვს თავისი დამახასიათებელი ნიშნები კანის ბიოფსიით და მათი იდენტიფიცირება შესაძლებელია იმუნოფლუორესცენტული და ანტისხეულების კვლევებით. კანის ბიოფსიის ან შრატის იმუნოფლუორესცენტული კვლევები დაადასტურებს ორსულობის პემფიგოიდის დიაგნოზს.
ალერგიული/იმუნური დაავადება
ალერგიული ბრონქოპულმონური ასპერგილოზი დაკავშირებულია IgE მომატებულ დონესთან. ასპერგილოზზე კანის ტესტით დამახასიათებელია კანის დაუყოვნებელი ჰიპერსენსიტიურობა. გულმკერდის რენტგენოგრაფიით შესაძლოა გამოვლინდეს ფილტვის ინფილტრაცია, ხოლო გულმკერდის მაღალი გარჩევადობის კტ სკანირებამ შეიძლება აჩვენოს ცენტრალური ბრონქოექტაზია და ზოგჯერ ბრონქიოლების ლორწოთი დაცობა.[27]
პოლიანგიიტით მიმდინარე ეოზინოფილური გრანულომატოზის დროს გულმკერდის რენტგენოგრაფიამ შეიძლება აჩვენოს რეტიკულონოდულური ინფილტრაცია, პლევრული გამონაჟონი და ლიმფადენოპათია. სინუსების რენტგენოგრამაზე ხშირია სინუსიტისთვის დამახასიათებელი ნიშნები (დაზიანებული სინუსების დაჩრდილვა, ლორწოვანი გარსის გასქელება, ჰაერი- სითხის დონე ან ანატომიური პათოლოგიები). ეოზინოფილიასთან ერთად როგორც წესი, აღინიშნება ნორმოციტული ნორმოქრომული ანემია და მომატებული ედს და C-რეაქტიული ცილა. სხვა არასპეციფიკური ნიშნებია: დადებითი შედეგი ანტინეიტროფილურ ციტოპლაზმურ ანტისხეულებზე, ანტინუკლეურ ანტისხეულებზე, რევმატოიდულ ფაქტორზე და იმუნოგლობულინების, განსაკუთრებით, IgE მომატებული დონე. დაზიანებული ქსოვილის ბიოფსიით აღინიშნება მანეკროზებელი ვასკულიტი ეოზინოფილების ინფილტრაციით და ზოგჯერ გრანულომების წარმოქმნით.[28][29]
ეოზინოფილური ეზოფაგიტის და ეოზინოფილური გასტროენტერიტის დიაგნოსტიკისთვის აუცილებელია კუჭ-ნაწლავის ენდოსკოპია ბიოფსიით.
გამოხატული ეოზინოფილია (>3.0 x10⁹/ლ [>3000/მიკროლიტრში])
ძიმე ეოზინოფილია, განსაკუთრებით ეოზინოფილია >3.0 × 10⁹/ლ (>3000/მიკროლიტრი), ჩვეულებრივ ვარაუდობს:
პარაზიტული ინფექცია
მედიკამენტებზე ჰიპერმგრძნობელობა
ეოზინოფილური გრანულომატოზი პოლიანგიიტით
ჰოჯკინის ლიმფომა
მწვავე ლიმფობლასტური ლეიკემია
ეოზინოფილური ლეიკემია
იდიოპათიური ჰიპერეოზინოფილური სინდრომი.[Figure caption and citation for the preceding image starts]: პაციენტების სისხლის ნაცხში რეაქტიული ეოზინოფილია პასუხია მწვავე ლიმფოციტურ ლეიკემიაზე. ერთი ბლასტური უჯრედია. ეოზინოფილები ციტოლოგიურად პათოლოგიურიაბარბარა ჯ. ბეინის პერსონალური კოლექციიდან, MBBS, FRACP, FRCPath; გამოიყენება ნებართვით [Citation ends].
[Figure caption and citation for the preceding image starts]: FIP1L1-PDGFRA გენის შერწყმის შედეგად განვითარებული ქრონიკული ეოზინოფილური ლეიკემიის მქონე პაციენტის სისხლის ნაცხი. ეოზინოფილები ნაწილობრივ დეგრანულირებული და ერთი ჰიპოსეგმენტირებულიაბარბარა ჯ. ბეინის პერსონალური კოლექციიდან, MBBS, FRACP, FRCPath; გამოიყენება ნებართვით [Citation ends].
1.5 × 10⁹/ლ (1500/მიკროლიტრში) ზღვარი ტრადიციულდ მიჩნეულია იდიოპათიური ჰიპერეოზინოფილური სინდრომის დიაგნოსტიკურ ერთ კრიტერიუმად. სხვა კრიტერიუმებს მიეკუთვნება ეოზინოფილია 6 თვეზე მეტი ხნის განმავლობაში და ორგანოთა დაზიანების ნიშნები, ეოზინოფილიის სხვა მიზეზი არ არის ნაპოვნი.[2][24]იგივე ზღვრული მაჩვენებელი 1.5 × 10⁹/ლ (1500/მიკროლიტრი) გამოყენებული იყო ქრონიკული ეოზინოფილური ლეიკემიის განსაზღვრების ფარგლებში.[30][31]
იდიოპათიური ჰიპერეოზინოფილური სინდრომი უნდა დიაგნოსტირდეს ყველა იდენტიფიცირებადი მიზეზის გამორიცხვის შემდეგ. თუ გამოხატული ეოზინოფილია (მაგ., ≥1.5 × 10⁹/ლ [1500/მიკროლიტრში]) იწვევს ქსოვილების დაზიანებას და გამოირიცხება ეოზინოფილიის ხშირი მიზეზები, ასევე რელევანტურია ყველა იშვიათი მიზეზის გამორიცხვა, რადგან ზოგიერთი მათგანი სიცოცხლისთვის საშიშია და საჭიროებს სპეციფიკურ მკურნალობას.
ამ მასალის გამოყენება ექვემდებარება ჩვენს განცხადებას